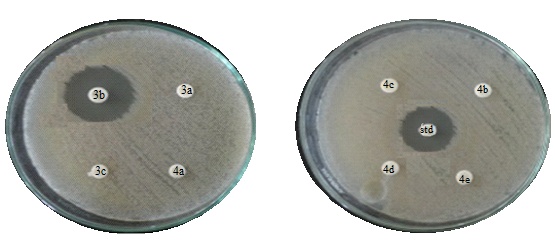

Int J Pharm Pharm Sci, Vol 8, Issue 6, 289-291Short Communication
SYNTHESIS CHARACTERISATION AND BIOLOGICAL EVALUATION OF (3Z, 4Z)-3, 4-BIS (SUBSTITUTED PHENYL BENZYLIDINE)-1-(4-SUBTITUTED PHENYL) PYROLIDINE-2, 5-DIONE
S. S. PATOLE1, S. S. RAJPUT2
1Department of Chemistry S. S. V. P. S College Shindkheda, Dist-Dhule, Maharashtra, India, 2Department of Chemistry S. V. S’S Dadasaheb Rawal College Dondaicha, Maharashtra, India
Email: sandippatole@yahoo.co.in
Received: 07 May 2015 Revised and Accepted: 20 Apr 2016
ABSTRACT
Objective: The present study focuses on synthesis and characterization of new series of bis-chalcone derivatives from cyclic imides and evaluating its antimicrobial activity against a pathogenic microorganism.
Methods: The substituted cyclic imides 4-methyl phenyl pyrrolidine 2,5 dione 1 and 4-methoxy phenyl pyrrolidine 2,5 dione 2 were synthesized from succinic acid and primary aromatic amines. These cyclic imides condensed with substituted benzaldehydes in the presence of acetic acid furnished bis-heterocyclic chalcones and characterized by FT-IR, 1H NMR and also microbial activity was determined using the disc diffusion method.
Results: The antimicrobial activity of bis-heterocyclic chalcones was tested against selective pathogens and the zone of inhibition was observed in E. coli, C. albicans and A. niger at 100µg/ml concentration.
Conclusion: The compound (3Z,4Z)-3,4-bis-(2-hydroxybenzylidine)-1-p-tolylpyrrolidine-2,5-dione (3b) with methyl and hydroxyl substituent on benzene ring exhibited good antibacterial activity against E. coli and potent antifungal activity againstC. albicans and A. niger.
Keywords: Succinic acid, Cyclic imides, Pyrrolidine-2,5-dione, Bis-chalcone
© 2016 The Authors. Published by Innovare Academic Sciences Pvt Ltd. This is an open access article under the CC BY license (http://creativecommons.org/licenses/by/4.0/)
Chalcones were synthesized by Claisen Schimidth condensation [1] reaction of an aldehyde with acetophenone in the presence of the suitable condensing agent, which involved cross aldol condensation. The Chalcone is very good synthon for the synthesis of a variety of heterocyclic compounds [2] having a therapeutic use. The chalcone possesses diverse pharmaceutical application such as Anti-inflammatory [3], Cytotoxic and Antioxidant [4], Antimicrobial [5], Analgesic [6], Anticonvulsant [7] and Anticancer [8]. In recent era the chemistry of imides has been extensively studied because of their industrial and pharmaceutical uses. The imides derivatives have been suggested for treatment of tuberculosis [9]. These are used in soap industry as a brightening agent in laundry industry [10]. The imide possesses antibacterial activity [11]. In this view, we have planned to synthesized bis-chalcone with imide moiety.
All chemicals used in the present work are of synthetic grade (Loba). The melting points were taken in open capillaries and are uncorrected. The I. R spectra were recorded on FTIR Shimadzu spectrophotometer using KBr disc method. The 1H NMR spectra were recorded on Brukar mx-500 MHz in CDCl3 and the chemical shift was recorded in δ unit relative to TMS as an internal standard.
Synthesis of 4-methyl phenyl pyrolidine2, 5 diones 1
A mixture of succinic acid 0.1 M (11.8 gm) and thionyl chloride 2.2 M (15 ml) was refluxed for 30 min and P-toludiene 0.1 M (10.70 gm) was dissolved in a suitable amount of benzene. The solution of P-toludiene added dropwise into the reaction mixture. The reaction mixture was then refluxed till complete evolution of HCl gas. Thus, crude product was obtained and recrystallized from ethanol. Yield 80.84 %; M. P 116-118 °C; IR (KBr, cm-1): 1700.31 (C=O), 2931.90 (C-H of CH3).
Synthesis of 4-methyl phenyl pyrrolidine 2, 5 dione 2
A mixture of succinic acid 0.1M (11.8 gm) and thionyl chloride 2.2 M (15 ml) was refluxed for 30 min and P-methoxy aniline 0.1 M (12.3 gm) was dissolved in a suitable amount of benzene. The solution of P-methoxy aniline added dropwise into reaction mixture. The reaction mixture was then refluxed till complete evolution of HCl gas. Thus, crude product was obtained recrystallized form ethanol. Yield 61.95 %; M. P 230 °C; IR (KBr, cm-1):1700.31 (C=O), 2841 (C-H of OCH3).
General procedure for bis-chalcone synthesis
Substituted phenyl pyrrolidine 2,5 dione (0.01M) and (0.02M) of substituted benzaldehyde in 15 ml acetic acid taken in conical flask. The reaction mixture was heated on sand bath for 15-20 min and kept it for overnight at room temperature. The solid obtained was filtered and recrystallised from ethanol.
(3Z,4Z)-3,4-bis(2-chlorobenzylidine)-1-p-tolylpyrrolidine-2,5-dione (3a)
Yield (69 %); M. P 173-175 °C; IR (KBr, cm-1): 1697.41 (C=O), 1631 (Ar, C=C), 716.58 (C-Cl); 1H NMR (CDCl3):δ: 8.22-6.43 (m,6H, Ar-H and =CH), 2.38 (s,3H,CH3). Anal. Calcd for C25H17Cl2NO2: C, 69.14; H, 3.95; N, 2.23%; Found: C, 69.25; H, 3.98; N, 2.31%.
(3Z,4Z)-3,4-bis(2-hydroxybenzylidine)-1-p-tolylpyrrolidine-2,5-dione (3b)
Yield (85%); M. P 166-168 °C; IR (KBr, cm-1): 1707.06 (C=O), 3462.34 (-OH) 2932.78 (CH of CH3); 1H NMR (CDCl3): δ: 2.40 (s, 3H, CH3), 5.1 (s, OH), 7.31-7.17(m,6H, Ar-H and =CH). Anal. Calcd for C25H19NO4: C, 75.55; H, 4.82; N, 3.52%. Found: C, 75.63; H, 4.88; N, 3.59%.
(3Z,4Z)-3,4-bis(3-nitrobenzylidine)-1-p-tolylpyrrolidine-2,5-dione (3c)
Yield (80 %); M. P 198-200 °C; IR (KBr, cm-1): 1707 (C=O), 1291.39 (C-NO2), 804 (Ar, C-H); 1H NMR (CDCl3):δ: 8.47-6.67 (m,6H, Ar-H and =CH), 2.30 (s, 3H, CH3); Anal. Calcd for C25H17N3O6: C, 65.93; H, 3.76; N, 9.23%; Found: C, 65.97; H, 3.82; N, 9.31%.
(3Z,4Z)-3,4-bis(3-nitrobenzylidine)-1-(4-methoxyphenyl) pyrrolidine-2,5-dione(4a)
Yield (76 %); M. P 158-160 °C; IR (KBr, cm-1): 1707 (C=O), 1534.42(C-NO2), 2839.78 (C-H, O-CH3);1H NMR (CDCl3): δ: 7.28-7.0 (m,7H, Ar-H and =CH), 3.85 (s, 3H, OCH3); Anal. Calcd for C25H17N3O7: C, 63.69; H, 3.63; N, 8.91%; Found: C, 63.8; H, 3.76; N, 8.96%.
(3Z,4Z)-3,4-bis(2-chlorobenzylidine)-1-(4-methoxyphenyl) pyrrolidine-2,5-dione(4b)
Yield (69 %); M. P 164-166 °C, IR (KBr,cm-1):1697.41 (C=O cyclic imide), 716.5 (C-Cl), 2840.28 (C-H, O-CH3),1631.83(Ar, C=C);1H NMR (CDCl3):δ: 7.28-6.99 (m,7H, Ar-H and =CH), 3.84 (s, 3H, OCH3); Anal. Calcd for C25H17Cl2NO3: C, 66.68; H, 3.81; Cl, 15.75; N, 3.11%; Found: C, 66.78; H, 3.92; Cl, 15.87; N, 3.31%.
(3Z, 4Z)-3, 4-bis (4-methylbenzylidine)-1-(4-methoxyphenyl) pyrrolidine-2,5-dione (4c)
Yield (89 %); M. P 154-160 °C; IR (KBr, cm-1): 1705.13 (C=O cyclic imide), 2840.78 (C-H, O-CH3), 2937.68 (C-H of CH3), 1608.69(Ar, C=C); 1H NMR (CDCl3): δ: 7.28-7.0 (m,7H, Ar-H and =CH), 3.85(s, 3H, OCH3), 2.44 (s,3H,CH3); Anal. Calcd for C27H23NO3: C, 79.20; H, 5.66; N, 3.42%; Found: C, 79.51; H, 5.73; N, 3.59%.
(3Z,4Z)-3,4-bis(2-hydroxybenzylidine)-1-(4-methoxyphenyl) pyrrolidine-2,5-dione(4d)
Yield (69 %); M. P 150-152 °C; IR (KBr, cm-1): 1708.99 (C=O cyclic imide), 2841.24 (C-H, O-CH3), 3462.34 (-OH), 1608.69 (Ar, C=C); 1H NMR (CDCl3):δ: 7.28-6.99 (m,7H, Ar-H and =CH), 5.4 δ (s, OH) 3.85 (s, 3H, OCH3); Anal Calcd for C25H19NO5: C,72.62; H,4.63; N,3.99%; Found: C,72.81; H,4.77; N,3.46%.
(3Z,4Z)-3,4-bis(4-mthoxybenzylidine)-1-(4-methoxyphenyl) pyrrolidine-2, 5-dione (4e)
Yield (71 %); M. P 162-164 °C; IR (KBr, cm-1): 1705.13 (C=O cyclic imide), 1178.25 (C-O, OCH3), 2920.32 (C-H, O-CH3), 1512.24 (Ar, C=C); 1H NMR (CDCl3):δ: 7.28-6.99 (m,7H, Ar-H and =CH), 3.85 (s, 3H, OCH3); Anal. Calcd for C27H23NO5: C, 73.46; H, 5.25; N, 3.73%; Found: C, 73.62; H, 5.47; N, 3.8%.

The cyclic imides 1 and 2 are required for synthesis of bis-heterocyclic chalcones were prepared by reaction of the succinic acid with thionly chloride. To provide succinyl chloride in situ this was condensed with P-toludiene and P-methoxy aniline in the presence of benzene (Scheme 1). The IR spectra of compound 1 shows frequency at 1700.31 Cm-1 is due to the presence of cyclic five-membered imide group CO-N-CO and 2931.90 Cm-1 is corresponded to C-H stretching frequency of–CH3 group. The 1H NMR Spectrum in CDCl3 shows a characteristic peak of four succinamide protons shows peak around 2.8 δ and methyl proton at aromatic ring shows singlet at 2.33 δ.

The IR spectra of compound 2 shows frequency at 1700.31 Cm-1 due to the presence of cyclic five-membered imide group CO-N-CO. The 1H NMR Spectrum in CDCl3 shows a characteristic peak of methoxy proton as a singlet at 3.8 δ. The bis-heterocyclic compounds 3a-c were synthesized by reaction of compound 1 with O-chloro- benzaldehyde, O-hydroxy benzaldehyde, M-nitrobenzaldehyde in the presence of acetic acid (Scheme 2). The imide 2 Condensed with M-nitrobenzaldehyde, O-chloro- benzaldehyde, P-methyl benzaldehyde, O-hydroxy benzaldehyde and P-methoxy benzaldehyde in the presence of acetic acid furnished into bis-heterocyclic chalcone 4a-c (Scheme 3).
All synthesized compounds 3a-c and 4a-e were evaluated in–vitro against bacterial strains Gram-positive bacteria Staphylococcus aureus and Bacillus subtilis, Gram-negative bacteria Escherichia coli and pseudomonas aeuroginosa [12]. The solvent DMSO was used to prepared aliquots of 3a-c and 4a-e compounds and the final concentration 100µg/ml per disc was adjusted. The disc diffusion method was used to evaluate antimicrobial activity. For this, nutrient agar was employed as culture media. The results were obtained in the form of a zone of inhibition and were noted after the period of incubation (at 37 °C for 24-28 h).
Table 1: It shows microbial evaluation (zone if inhibition in mm) of compound 3a-c and 4a-e
Compound |
E. coli |
P. aeruginosa |
S. aureus |
B. subtilis |
C. albicans |
A. niger |
3a |
NA |
NA |
NA |
NA |
NA |
NA |
3b |
15.23±1.11 |
NA |
NA |
NA |
12.35±1.01 |
15.28±1.08 |
3c |
NA |
NA |
NA |
NA |
NA |
NA |
4a |
NA |
NA |
NA |
NA |
NA |
NA |
4b |
NA |
NA |
NA |
NA |
NA |
NA |
4c |
NA |
NA |
NA |
NA |
NA |
NA |
4d |
NA |
NA |
NA |
NA |
NA |
NA |
4e |
NA |
NA |
NA |
NA |
NA |
NA |
Ciprofloxacin |
19.59±1.30 |
9.33±1.17 |
18.27±1.17 |
21.28±1.09 |
- |
- |
Amphotericine-B |
- |
- |
- |
- |
11.25±1.15 |
11.63±1.05 |
Note: NA means No activity at 100µg/ml,-means Not applicable, n=3
Fig. 1: Agar plate exhibiting the zone of inhibition by compound (3Z,4Z)-3,4-bis(2-hydroxybenzylidine)-1-p-tolylpyrrolidine-2,5-dione (3b) against fungi A. nigar at 100µg/ml
The zone of inhibitions was measured in mm and similarly, compounds 3a-c and 4a-e were evaluated in–vitro against for antifungal activity against Fungi (Yeast) Candida albicans, Fungi (Mould) Aspergillus niger at the concentration 100µg/ml per disc by disc diffusion method using DMSO as a solvent. The experiment was in triplicate, average and standard deviation were calculated.
The antimicrobial results were compared with antibiotic Ciprofloxacin and Amphotericine-B as standard and summarized in table 1. Literature survey suggested that chalcone derivative having hydroxyl substituent did not shows antibacterial activities at about 1000 µg/ml concentration [13] but in present work the synthesized bis-heterocyclic chalcone 3b possessing hydroxyl substituent display promising antibacterial activity against Escherichia coli at only 100 µg/ml concentration.
CONCLUSION
The study concluded that among all synthesized compounds the compound (3Z,4Z)-3,4-bis(2-hydroxybenzylidine)-1-p-tolylpyrrolidine- 2,5-dione (3b) exhibited good antibacterial activity against E. coli, and potent antifungal activity against Candida albicans and Aspergillus niger. The remaining compound does not exhibited microbial activities 100µg/ml concentration.
ACKNOWLEDGEMENT
The authors are thankful to the department of chemistry, Savitri bai Phule Pune University for providing spectral analysis facilities. Department of microbiology R. C. Patel College shirpur for providing biological evaluation facilities.
CONFLICT OF INTERESTS
Declared none
REFERENCES
- Kartizsky AR, Pozharskii AF. Handbook of heterocyclic Chemistry. Edition 2nd. Pergamum-NY; 2000.
- Solankee AN, Patel GA. Synthesis characterization and antibacterial activity of some novel isoxazoles, pyrimidinthiones, and pyrimidinones. Int J Pharm Biol Sci 2011;2:163-9.
- Hatem A, Abdel AA, Khalid A. Microwave-assisted Synthesis of Novel 3,4-Bis-chalcone-N-aryl pyrazoles and their anti-inflammatory activity. Chin J Chem Soc 2011;58:863-8.
- Singh S, Sharm PK, Kumar N, Dudhe R. Antioxidant activity of 2-hydroxyacetophenone Chalcone. J Adv Sci Res 2011;2:37-41.
- Prasadarao K, Lusirani Susuma AJ, Mohan S. Synthesis characterization and antibacterial activity of few chalcone. Int J Pharm Biol Sci 2012;34:781–8.
- Correa R, Filho VC, Rosa PW, Pereira CI, Schlemper V, Nunes RJ. Synthesis of new succinimides and sulfonated derivatives with analgesic action in mice. Pharmacogn Commun 1997;32:67-1.
- Singh A, Rana AC. Synthesis and anticonvulsant activity of 1-(4, 5-dihydro-5-phenyl-3-(phenylamino) pyrazol-1-yl) ethanone derivatives. J Chem Pharm Res 2010;21:505-11.
- Selvi RS, Nanthini R, Sukanyaa G. Synthesis and in vitro evaluation of copolyester chalcone derivatives as potential anticancer agents. Int J Basic Appl Med Sci 2011;1:18-22.
- Patil MM, Rajput SS. Succinimides synthesis reaction and biological activity. Int J Pharm Pharm Sci 2014;6:8-14.
- Rajput SS. Synthesis and characterization of bis-heterocyclic derivatives of 1-3-Chlorophenyl-Pyrrolidine-2, 5-dione. Int J Appl Pharm Biol Chem 2012;12:242-6.
- Dhivare RS, Rajput SS. Synthesis and antimicrobial activity of five-membered cyclic imide derivatives of mono di and tri-substituted aromatic amines and naphthyl amine. World J Pharm Res 2014;4:1650-8.
- Vanati P, Rajiv P, Rajeshwari S. Eichhornia mediated copper oxide nanoparticles in vitro analysis of antimicrobial activity. Int J Pharm Pharm Sci 2015;7:422-4.
- Rao AS, Siman L, Srinivasan KK, Moorkoth S, Haleem ZA, Jadon SS, et al. Synthesis and in vitro antimicrobial evaluation of 5-Acetamido-2-Hydroxy Chalcone derivative. Res J Chem Sci 2014;4:56-9.